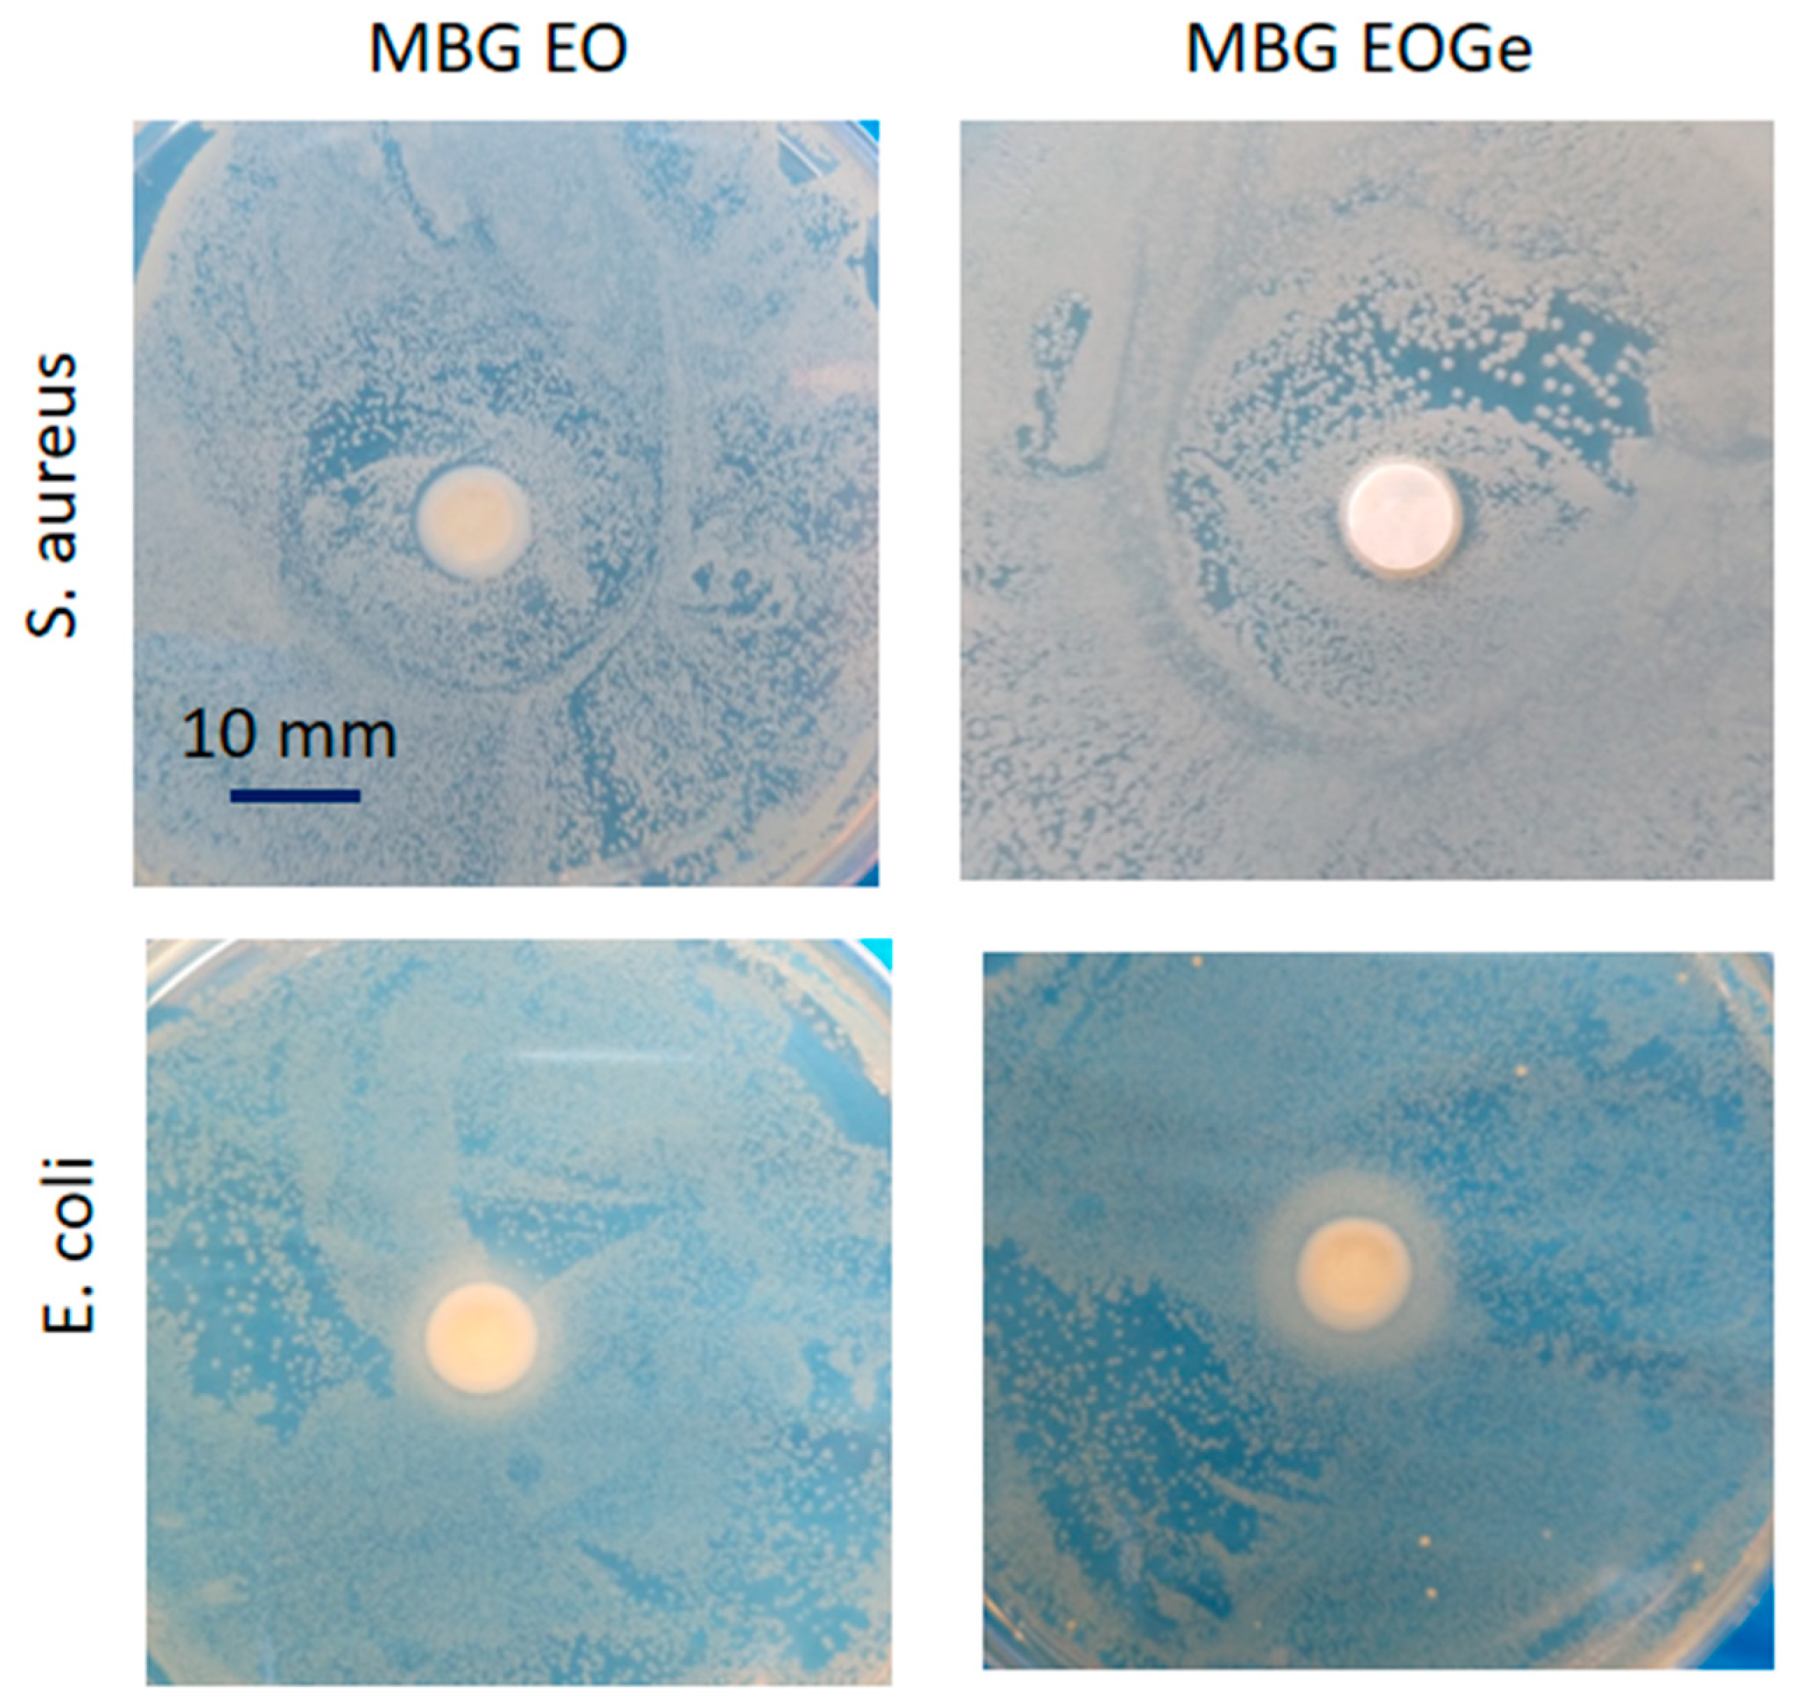
Nanomaterials 13 00034 g010 Nanomaterials 13 00034 g010

Melaleuca armillaris Essential Oil as an Antibacterial Agent: The Use of Mesoporous Bioactive Glass Nanoparticles as Drug Carrier
Abstract
1. Introduction
2. Materials and Methods
2.1. Melaleuca armillaris Essential Oil Extraction
2.2. Synthesis of Mesoporous Bioactive Glass (MBG) Particles
2.3. EO and Drug Load into MBG Particles
2.4. Coating of Loaded MBG Particles
2.5. Particles Characterization
2.6. EO Encapsulation Percentage/Release
2.7. In Vitro Apatite Formation Ability
2.8. Antibacterial Behaviour
3. Results and Discussion
4. Conclusions
Author Contributions
Funding
Acknowledgments
Conflicts of Interest
References
- Hench, L.L. Bioceramics: From Concept to Clinic. J. Am. Ceram. Soc. 1991, 74, 1487–1510. [Google Scholar] [CrossRef]
- Hench, L.L.; Polak, J.M. Third-Generation Biomedical Materials. Science 2002, 295, 1014+1016–1017. [Google Scholar] [CrossRef] [PubMed]
- Jones, J.R. Review of Bioactive Glass: From Hench to Hybrids. Acta Biomater. 2013, 9, 4457–4486. [Google Scholar] [CrossRef] [PubMed]
- Hoppe, A.; Güldal, N.S.; Boccaccini, A.R. A Review of the Biological Response to Ionic Dissolution Products from Bioactive Glasses and Glass-Ceramics. Biomaterials 2011, 32, 2757–2774. [Google Scholar] [CrossRef] [PubMed]
- Hench, L.L. The Story of Bioglass. J. Mater. Sci. Mater. Med. 2006, 17, 967–978. [Google Scholar] [CrossRef]
- Nawaz, Q.; Rehman, M.A.U.; Burkovski, A.; Schmidt, J.; Beltrán, A.M.; Shahid, A.; Alber, N.K.; Peukert, W.; Boccaccini, A.R. Synthesis and Characterization of Manganese Containing Mesoporous Bioactive Glass Nanoparticles for Biomedical Applications. J. Mater. Sci. Mater. Med. 2018, 29, 64. [Google Scholar] [CrossRef]
- Crush, J.; Hussain, A.; Seah, K.T.M.; Khan, W.S. Bioactive Glass: Methods for Assessing Angiogenesis and Osteogenesis. Front. Cell Dev. Biol. 2021, 9, 643781. [Google Scholar] [CrossRef]
- Xynos, I.D.; Edgar, A.J.; Buttery, L.D.K.; Hench, L.L.; Polak, J.M. Ionic Products of Bioactive Glass Dissolution Increase Proliferation of Human Osteoblasts and Induce Insulin-like Growth Factor II MRNA Expression and Protein Synthesis. Biochem. Biophys. Res. Commun. 2000, 276, 461–465. [Google Scholar] [CrossRef]
- Shie, M.-Y.; Ding, S.-J.; Chang, H.-C. The Role of Silicon in Osteoblast-like Cell Proliferation and Apoptosis. Acta Biomater. 2011, 7, 2604–2614. [Google Scholar] [CrossRef]
- Vallet-Regí, M.; Balas, F.; Arcos, D. Mesoporous Materials for Drug Delivery. Angew. Chemie—Int. Ed. 2007, 46, 7548–7558. [Google Scholar] [CrossRef]
- Sepulveda, P.; Jones, J.R.; Hench, L.L. In Vitro Dissolution of Melt-Derived 45S5 and Sol-Gel Derived 58S Bioactive Glasses. J. Biomed. Mater. Res. 2002, 61, 301–311. [Google Scholar] [CrossRef]
- Kargozar, S.; Montazerian, M.; Hamzehlou, S.; Kim, H.-W.; Baino, F. Mesoporous Bioactive Glasses: Promising Platforms for Antibacterial Strategies. Acta Biomater. 2018, 81, 1–19. [Google Scholar] [CrossRef]
- Dash, M.; Chiellini, F.; Ottenbrite, R.M.; Chiellini, E. Chitosan—A Versatile Semi-Synthetic Polymer in Biomedical Applications. Prog. Polym. Sci. 2011, 36, 981–1014. [Google Scholar] [CrossRef]
- Avershina, E.; Shapovalova, V.; Shipulin, G. Fighting Antibiotic Resistance in Hospital-Acquired Infections: Current State and Emerging Technologies in Disease Prevention, Diagnostics and Therapy. Front. Microbiol. 2021, 12, 2044. [Google Scholar] [CrossRef]
- Khameneh, B.; Iranshahy, M.; Soheili, V.; Fazly Bazzaz, B.S. Review on Plant Antimicrobials: A Mechanistic Viewpoint. Antimicrob. Resist. Infect. Control 2019, 8, 118. [Google Scholar] [CrossRef]
- Buldain, D.; Castillo, L.G.; Buchamer, A.V.; Aliverti, F.; Bandoni, A.; Marchetti, L.; Mestorino, N. Melaleuca Armillaris Essential Oil in Combination with Rifaximin Against Staphylococcus Aureus Isolated of Dairy Cows. Front. Vet. Sci. 2020, 7, 334. [Google Scholar] [CrossRef]
- Sharifi-Rad, J.; Salehi, B.; Varoni, E.M.; Sharopov, F.; Yousaf, Z.; Ayatollahi, S.A.; Kobarfard, F.; Sharifi-Rad, M.; Afdjei, M.H.; Sharifi-Rad, M.; et al. Plants of the Melaleuca Genus as Antimicrobial Agents: From Farm to Pharmacy. Phyther. Res. 2017, 31, 1475–1494. [Google Scholar] [CrossRef]
- Buldain, D.; Castillo, L.G.; Marchetti, M.L.; Lozano, K.J.; Bandoni, A.; Mestorino, N. Modeling the Growth and Death of Staphylococcus Aureus against Melaleuca Armillaris Essential Oil at Different Ph Conditions. Antibiotics 2021, 10, 222. [Google Scholar] [CrossRef]
- Tiji, S.; Lakrat, M.; Rokni, Y.; Mejdoubi, E.M.; Hano, C.; Addi, M.; Asehraou, A.; Mimouni, M. Characterization and Antimicrobial Activity of Nigella Sativa Extracts Encapsulated in Hydroxyapatite Sodium Silicate Glass Composite. Antibiotics 2022, 11, 170. [Google Scholar] [CrossRef]
- Schuhladen, K.; Roether, J.A.; Boccaccini, A.R. Bioactive Glasses Meet Phytotherapeutics: The Potential of Natural Herbal Medicines to Extend the Functionality of Bioactive Glasses. Biomaterials 2019, 217, 119288. [Google Scholar] [CrossRef]
- Galarraga-Vinueza, M.E.; Mesquita-Guimarães, J.; Magini, R.S.; Souza, J.C.M.; Fredel, M.C.; Boccaccini, A.R. Mesoporous Bioactive Glass Embedding Propolis and Cranberry Antibiofilm Compounds. J. Biomed. Mater. Res. Part A 2018, 106, 1614–1625. [Google Scholar] [CrossRef] [PubMed]
- Zheng, K.; Torre, E.; Bari, A.; Taccardi, N.; Cassinelli, C.; Morra, M.; Fiorilli, S.; Vitale-Brovarone, C.; Iviglia, G.; Boccaccini, A.R. Antioxidant Mesoporous Ce-Doped Bioactive Glass Nanoparticles with Anti-Inflammatory and pro-Osteogenic Activities. Mater. Today Bio 2020, 5, 100041. [Google Scholar] [CrossRef] [PubMed]
- Pontremoli, C.; Pagani, M.; Maddalena, L.; Carosio, F.; Vitale-Brovarone, C.; Fiorilli, S. Polyelectrolyte-Coated Mesoporous Bioactive Glasses via Layer-by-Layer Deposition for Sustained Co-Delivery of Therapeutic Ions and Drugs. Pharmaceutics 2021, 13, 1952. [Google Scholar] [CrossRef] [PubMed]
- Gomez Sanchez, A.; Katunar, M.R.; Pastore, J.I.; Tano de la Hoz, M.F.; Ceré, S. Evaluation of Annealed Titanium Oxide Nanotubes on Titanium: From Surface Characterization to in Vivo Assays. J. Biomed. Mater. Res. Part A 2021, 109, 1088–1100. [Google Scholar] [CrossRef] [PubMed]
- Gonzalez Galdos, M.V.; Pastore, J.I.; Ballarre, J.; Ceré, S.M. Dual-Surface Modification of Titanium Alloy with Anodizing Treatment and Bioceramic Particles for Enhancing Prosthetic Devices. J. Mater. Sci. 2017, 52, 9151–9165. [Google Scholar] [CrossRef]
- Aydemir, T.; Liverani, L.; Pastore, J.I.; Ceré, S.M.; Goldmann, W.H.; Boccaccini, A.R.; Ballarre, J. Functional Behavior of Chitosan/Gelatin/Silica-Gentamicin Coatings by Electrophoretic Deposition on Surgical Grade Stainless Steel. Mater. Sci. Eng. C 2020, 115, 111062. [Google Scholar] [CrossRef]
- Meng, Y.; Zhang, Z.; Yin, H.; Ma, T. Automatic Detection of Particle Size Distribution by Image Analysis Based on Local Adaptive Canny Edge Detection and Modified Circular Hough Transform. Micron 2018, 106, 34–41. [Google Scholar] [CrossRef]
- Glueck, D.H. Sample Size Calculations in Clinical Research 2nd Edition by CHOW, S.-C., SHAO, J., and WANG, H. Biometrics 2008, 64, 1307–1308. [Google Scholar] [CrossRef]
- Kokubo, T.; Takadama, H. How Useful Is SBF in Predicting in Vivo Bone Bioactivity? Biomaterials 2006, 27, 2907–2915. [Google Scholar] [CrossRef]
- Jiménez-Holguín, J.; López-Hidalgo, A.; Sánchez-Salcedo, S.; Peña, J.; Vallet-Regí, M.; Salinas, A.J. Strontium-Modified Scaffolds Based on Mesoporous Bioactive Glasses/Polyvinyl Alcohol Composites for Bone Regeneration. Materials 2020, 13, 5526. [Google Scholar] [CrossRef]
- Novak, S.; Orives, J.R.; Nalin, M.; Unalan, I.; Boccaccini, A.R.; de Camargo, E.R. Quaternary Bioactive Glass-Derived Powders Presenting Submicrometric Particles and Antimicrobial Activity. Ceram. Int. 2022, 48, 29982–29990. [Google Scholar] [CrossRef]
- Yan, R.; Yang, Y.; Zeng, Y.; Zou, G. Cytotoxicity and Antibacterial Activity of Lindera Strychnifolia Essential Oils and Extracts. J. Ethnopharmacol. 2009, 121, 451–455. [Google Scholar] [CrossRef]
- Zhang, Y.; Newton, B.; Lewis, E.; Fu, P.P.; Kafoury, R.; Ray, P.C.; Yu, H. Cytotoxicity of Organic Surface Coating Agents Used for Nanoparticles Synthesis and Stability. Toxicol. Vitr. Int. J. Publ. Assoc. BIBRA 2015, 29, 762–768. [Google Scholar] [CrossRef]
- Wang, Y.; Zhao, Q.; Han, N.; Bai, L.; Li, J.; Liu, J.; Che, E.; Hu, L.; Zhang, Q.; Jiang, T.; et al. Mesoporous Silica Nanoparticles in Drug Delivery and Biomedical Applications. Nanomed. Nanotechnol. Biol. Med. 2015, 11, 313–327. [Google Scholar] [CrossRef]
- Pawlak, A.; Mucha, M. Thermogravimetric and FTIR Studies of Chitosan Blends. Thermochim. Acta 2003, 396, 153–166. [Google Scholar] [CrossRef]
- Witecka, A.; Valet, S.; Basista, M.; Boccaccini, A.R. Electrophoretically Deposited High Molecular Weight Chitosan/Bioactive Glass Composite Coatings on WE43 Magnesium Alloy. Surf. Coat. Technol. 2021, 418, 127232. [Google Scholar] [CrossRef]
- Shahriarinour, M.; Divsar, F.; Eskandari, Z. Synthesis, Characterization, and Antibacterial Activity of Thymol Loaded SBA-15 Mesoporous Silica Nanoparticles. Inorg. Nano-Metal Chem. 2019, 49, 182–189. [Google Scholar] [CrossRef]
- Corvini, N.; El Idrissi, M.; Dimitriadou, E.; Corvini, P.F.-X.; Shahgaldian, P. Hydrophobicity-Responsive Engineered Mesoporous Silica Nanoparticles: Application in the Delivery of Essential Nutrients to Bacteria Combating Oil Spills. Chem. Commun. 2019, 55, 7478–7481. [Google Scholar] [CrossRef]
- Poyatos-Racionero, E.; Guarí-Borràs, G.; Ruiz-Rico, M.; Morellá-Aucejo, Á.; Aznar, E.; Barat, J.M.; Martínez-Máñez, R.; Marcos, M.D.; Bernardos, A. Towards the Enhancement of Essential Oil Components’ Antimicrobial Activity Using New Zein Protein-Gated Mesoporous Silica Microdevices. Int. J. Mol. Sci. 2021, 22, 3795. [Google Scholar] [CrossRef]
- Ukmar, T.; Maver, U.; Planinšek, O.; Kaučič, V.; Gaberšček, M.; Godec, A. Understanding Controlled Drug Release from Mesoporous Silicates: Theory and Experiment. J. Control. Release 2011, 155, 409–417. [Google Scholar] [CrossRef]
- Sahoo, T.R.; Prelot, B. Chapter 7—Adsorption Processes for the Removal of Contaminants from Wastewater: The Perspective Role of Nanomaterials and Nanotechnology. In Nanomaterials for the Detection and Removal of Wastewater Pollutants; Bonelli, B., Freyria, F.S., Rossetti, I., Sethi, R., Eds.; Micro and Nano Technologies; Elsevier: Amsterdam, The Netherlands, 2020; pp. 161–222. ISBN 978-0-12-818489-9. [Google Scholar]
- Dardir, F.M.; Ahmed, E.A.; Soliman, M.F.; Othman, S.I.; Allam, A.A.; Alwail, M.A.; Abukhadra, M.R. Synthesis of Chitosan/Al-MCM-41 Nanocomposite from Natural Microcline as a Carrier for Levofloxacin Drug of Controlled Loading and Release Properties; Equilibrium, Release Kinetic, and Cytotoxicity. Colloids Surf. A Physicochem. Eng. Asp. 2021, 624, 126805. [Google Scholar] [CrossRef]
- Schumacher, M.; Habibovic, P.; van Rijt, S. Mesoporous Bioactive Glass Composition Effects on Degradation and Bioactivity. Bioact. Mater. 2021, 6, 1921–1931. [Google Scholar] [CrossRef] [PubMed]
- Ohtsuki, C.; Kokubo, T.; Yamamuro, T. Compositional Dependence of Bioactivity of Glasses in the System CaO-SiO2-Al2O3: Its in Vitro Evaluation. J. Mater. Sci. Mater. Med. 1992, 3, 119–125. [Google Scholar] [CrossRef]
- Ohtsuki, C.; Kushitani, H.; Kokubo, T.; Kotani, S.; Yamamuro, T. Apatite Formation on the Surface of Ceravital—Type Glass—Ceramic in the Body. J. Biomed. Mater. Res. 1991, 25, 1363–1370. [Google Scholar] [CrossRef] [PubMed]
- Balamurugan, A.; Sockalingum, G.; Michel, J.; Fauré, J.; Banchet, V.; Wortham, L.; Bouthors, S.; Laurent-Maquin, D.; Balossier, G. Synthesis and Characterisation of Sol Gel Derived Bioactive Glass for Biomedical Applications. Mater. Lett. 2006, 60, 3752–3757. [Google Scholar] [CrossRef]
- Zheng, K.; Solodovnyk, A.; Li, W.; Goudouri, O.-M.; Stähli, C.; Nazhat, S.N.; Boccaccini, A.R. Aging Time and Temperature Effects on the Structure and Bioactivity of Gel-Derived 45S5 Glass-Ceramics. J. Am. Ceram. Soc. 2015, 98, 30–38. [Google Scholar] [CrossRef]
- Ye, J.; He, J.; Wang, C.; Yao, K.; Gou, Z. Copper-Containing Mesoporous Bioactive Glass Coatings on Orbital Implants for Improving Drug Delivery Capacity and Antibacterial Activity. Biotechnol. Lett. 2014, 36, 961–968. [Google Scholar] [CrossRef]
- Ciraldo, F.E.; Schnepf, K.; Goldmann, W.H.; Boccaccini, A.R. Development and Characterization of Bioactive Glass Containing Composite Coatings with Ion Releasing Function for Antibiotic-Free Antibacterial Surgical Sutures. Materials 2019, 12, 423. [Google Scholar] [CrossRef]
- Chotchindakun, K.; Pekkoh, J.; Ruangsuriya, J.; Zheng, K.; Unalan, I.; Boccaccini, A.R. Fabrication and Characterization of Cinnamaldehyde-Loaded Mesoporous Bioactive Glass Nanoparticles/PHBV-Based Microspheres for Preventing Bacterial Infection and Promoting Bone Tissue Regeneration. Polymers 2021, 13, 1794. [Google Scholar] [CrossRef]
- Ismail, A.; Mancini, E.; De Martino, L.; Marandino, A.; Hamrouni, L.; Hanana, M.; Jamoussi, B.; Mariarosa, S.; Reverchon, E.; De Feo, V. Chemical Composition and Biological Activities of the Essential Oils from Three Melaleuca Species Grown in Tunisia. Int. J. Mol. Sci. 2012, 13, 16580–16591. [Google Scholar] [CrossRef]
- Sharma, A.D.; Kaur, I.; Singh, N. Synthesis, Characterization, and In Vitro Drug Release and In Vitro Antibacterial Activity of O/W Nanoemulsions Loaded with Natural Eucalyptus Globulus Essential Oil. Int. J. Nanosci. Nanotechnol. 2021, 17, 191–207. [Google Scholar]
- Silva, N.C.C.; Júnior, A.F. Biological Properties of Medicinal Plants: A Review of Their Antimicrobial Activity. J. Venom. Anim. Toxins Incl. Trop. Dis. 2010, 16, 402–413. [Google Scholar] [CrossRef]
- Hemaiswarya, S.; Kruthiventi, A.K.; Doble, M. Synergism between Natural Products and Antibiotics against Infectious Diseases. Phytomedicine 2008, 15, 639–652. [Google Scholar] [CrossRef]
- Langeveld, W.T.; Veldhuizen, E.J.A.; Burt, S.A. Synergy between Essential Oil Components and Antibiotics: A Review. Crit. Rev. Microbiol. 2014, 40, 76–94. [Google Scholar] [CrossRef]
- Zhong, X.; Gao, F.; Wei, H.; Zhou, H.; Zhou, X. Functionalization of Mesoporous Silica as an Effective Composite Carrier for Essential Oils with Improved Sustained Release Behavior and Long-Term Antibacterial Performance. Nanotechnology 2021, 33, 035706. [Google Scholar] [CrossRef]
- Zhang, D.; Leppäranta, O.; Munukka, E.; Ylänen, H.; Viljanen, M.K.; Eerola, E.; Hupa, M.; Hupa, L. Antibacterial Effects and Dissolution Behavior of Six Bioactive Glasses. J. Biomed. Mater. Res. A 2010, 93, 475–483. [Google Scholar] [CrossRef]
- Chaves, B.J.; Tadi, P. Gentamicin; StatPearls Publishing: Treasure Island, FL, USA, 2021. [Google Scholar]
- Man, A.; Santacroce, L.; Jacob, R.; Mare, A.; Man, L. Antimicrobial Activity of Six Essential Oils Against a Group of Human Pathogens: A Comparative Study. Pathogens 2019, 8, 15. [Google Scholar] [CrossRef]

| MBG | MBG EO | MBG EOGe | |
|---|---|---|---|
| Major axis | 0.29 ± 0.07 | 0.32 ± 0.08 | 0.30 ± 0.08 |
| Minor axis | 0.21 ± 0.05 | 0.22 ± 0.05 | 0.21 ± 0.05 |
| Type of Particle System | Qe | k2 | R2 |
|---|---|---|---|
| MBG EO | 36.09 | 7.04 × 10−3 | 0.99 |
| MBG EOGe | 24.16 | 5.92 × 10−3 | 0.99 |
| MBG EOGe chit | 11.05 | 5.15 × 10−3 | 0.98 |
Disclaimer/Publisher’s Note: The statements, opinions and data contained in all publications are solely those of the individual author(s) and contributor(s) and not of MDPI and/or the editor(s). MDPI and/or the editor(s) disclaim responsibility for any injury to people or property resulting from any ideas, methods, instructions or products referred to in the content. |
© 2022 by the authors. Licensee MDPI, Basel, Switzerland. This article is an open access article distributed under the terms and conditions of the Creative Commons Attribution (CC BY) license (https://creativecommons.org/licenses/by/4.0/).
Share and Cite
Ballarre, J.; Buldain, D.; Unalan, I.; Pastore, J.I.; Mestorino, N.; Boccaccini, A.R. Melaleuca armillaris Essential Oil as an Antibacterial Agent: The Use of Mesoporous Bioactive Glass Nanoparticles as Drug Carrier. Nanomaterials 2023, 13, 34. https://doi.org/10.3390/nano13010034
Ballarre J, Buldain D, Unalan I, Pastore JI, Mestorino N, Boccaccini AR. Melaleuca armillaris Essential Oil as an Antibacterial Agent: The Use of Mesoporous Bioactive Glass Nanoparticles as Drug Carrier. Nanomaterials. 2023; 13(1):34. https://doi.org/10.3390/nano13010034
Chicago/Turabian StyleBallarre, Josefina, Daniel Buldain, Irem Unalan, Juan I. Pastore, Nora Mestorino, and Aldo R. Boccaccini. 2023. "Melaleuca armillaris Essential Oil as an Antibacterial Agent: The Use of Mesoporous Bioactive Glass Nanoparticles as Drug Carrier" Nanomaterials 13, no. 1: 34. https://doi.org/10.3390/nano13010034
APA StyleBallarre, J., Buldain, D., Unalan, I., Pastore, J. I., Mestorino, N., & Boccaccini, A. R. (2023). Melaleuca armillaris Essential Oil as an Antibacterial Agent: The Use of Mesoporous Bioactive Glass Nanoparticles as Drug Carrier. Nanomaterials, 13(1), 34. https://doi.org/10.3390/nano13010034

